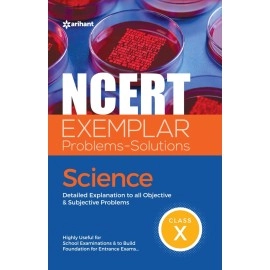
Arihant Publication India Limited NCERT Exemplar P..

- Best sellers
- New Arrivals
A Theory of Human Motivation (Hardcover Library Ed..
Arihant Publication Cbse All in One Ncert Based Ma..
Arihant Publication India Limited NCERT Exemplar P..
Arihant Publication India Limited NCERT EXEMPLAR P..
Arihant Publication India Limited NCERT Exemplar P..
CBSE
S. Chands Mental Mathematics For Class 1
Reading books is a kind of enjoyment. Reading books is a good habit. We bring you a different kinds of books. You can carry this book where ever you want. It is easy to carry. It can be an ideal gift to yourself and to your loved ones. Care instruction keep away from fire...
Arihant Publication India Limited NCERT EXEMPLAR Problems-Solutions Mathematics Class 8th
Questions are the root cause of success. The more new & authentic questions you will have, the more new & authentic knowledge you will have. Considering this fact, the Department of Education in Science & Mathematics (DESM) with an aim to improve the quality of teaching/learning process in schools has made an attempt to develop resource books of Ex..
Full Marks Mathematics CBSE Class 11 by Khem Chand Sisodia - Paperback
Product Features: Category Type: MathematicsAuthor: Khem Chand SisodiaAge Range: 5 to 9 YearsBinding: PaperbackBook Language: EnglishBook Origin: IndiaPublisher: Full Marks Pvt. Ltd.ISBN: 9789381957141..
Middle School English Grammar and Composition (MSEGC)
Wren and Martin\'s Middle School English Grammar and Composition is one of the most popular and widely used reference books on English Grammar...
Sparsh Bhag - 2 for Class - 10 Secondary Language (Dwitya Bhasha) Hindi Course Book - 1057
Sparsh Bhag - 2 for Class - 10 Secondary Language Dwitya Bhasha Hindi Course Book - 1057 National Council of Education Research and Training 20152015NCERT..
Nelson Thornes Ltd Nelson Grammar Pupil Book 2 Year 2/P3
Nelson Thornes Ltd Nelson Grammar Pupil Book 2 Year 2/P3..
Secondary School Mathematics For Class 9 (Examination 2020-2021)
Secondary School Mathematics For Class 9 (Examination 2020-2021)..
MTG Learning Media Pvt Ltd NCERT Text Book+Exemplar Problems-Solutions Mathematics Class 10
Reading books is a kind of enjoyment. Reading books is a good habit. We bring you a different kinds of books. You can carry this book where ever you want. It is easy to carry. It can be an ideal gift to yourself and to your loved ones. Care instruction keep away from fire...
Dhanpat Rai Publications Mathematics Class Vith(Based on the NCERT Syllabus) PB
Reading books is a kind of enjoyment. Reading books is a good habit. We bring you a different kinds of books. You can carry this book where ever you want. It is easy to carry. It can be an ideal gift to yourself and to your loved ones. Care instruction keep away from fire...
NCERT Exemplar Problems-Solutions Mathematics Class XII - Paperback
NCERT Exemplar Problems-Solutions Mathematics Class XII - Paperback..
Arihant Publication Cbse All in One Ncert Based Mathematics Class 7 for 2022 Exam
Arihant Publication Cbse All in One Ncert Based Mathematics Class 7 for 2022 Exam..
Rimjhim - Textbook in Hindi for Class - 4 - 423
Reading books is a kind of enjoyment. Reading books is a good habit. We bring you a different kinds of books. You can carry this book where ever you want. It is easy to carry. It can be an ideal gift to yourself and to your loved ones. Care instruction keep away from fire...
Cbse All in One Ncert Based Social Science Class 7 for 2022 Exam
Cbse All in One Ncert Based Social Science Class 7 for 2022 Exam..
Mathematics for Class 11 (Set of 2 Vol.)- CBSE - by R.D. Sharma Examination 2022-23: Vol. 2
Mathematics for Class 11 (Set of 2 Vol.)- CBSE - by R.D. Sharma Examination 2022-23: Vol. 2..
CBSE All In One NCERT Based Science Class 8 for 2022 Exam (Updated edition for Term 1 and 2)
1. All in One - bestselling series form Class 6th -12th 2. Covers complete theory, practice and assessment of Science for Class 8 3. The guide has been divided into 18 chapters giving coverage to the syllabus 4. Each Chapter is supported by detailed theory, illustrations, all types of questions 5. Chapter Practice given after each lesson for thorou..